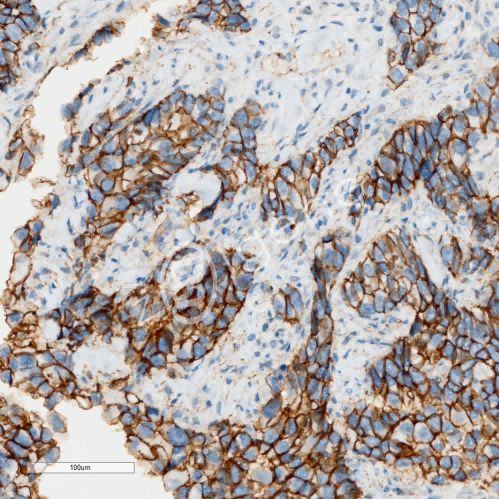
免疫组化（不含一抗）

万千商家帮你免费找货
0 人在求购买到急需产品
- 详细信息
- 技术资料
- 提供商:
载基生物
- 规格:
组织芯片/冰冻切片/石蜡切片/细胞爬片/大组织
| 规格: | 组织芯片 | 产品价格: | ¥110.0 |
|---|---|---|---|
| 规格: | 冰冻切片 | 产品价格: | ¥30.0 |
| 规格: | 石蜡切片 | 产品价格: | ¥30.0 |
| 规格: | 细胞爬片 | 产品价格: | ¥50.0 |
| 规格: | 大组织 | 产品价格: | ¥90.0 |
▶ 服务介绍
免疫组化,是应用免疫学基本原理——抗原抗体反应,即抗原与抗体特异性结合的原理,通过化学反应使标记抗体的显色剂(荧光素、酶、金属离子、同位素)显色来确定组织细胞内抗原(多肽和蛋白质),对其进行定位、定性及定量的研究,称为免疫组织化学技术(immunohistochemistry,IHC)或免疫细胞化学技术(immunocytochemistry)免疫组织化学。
▶ 服务介绍
2.具有多年免疫组化实验经验;
3.可免费使用我司细胞库、组织库已有细胞或石蜡切片,无需购买;
4.提供完整的实验数据及实验报告(包括实验仪器、试剂、方法步骤、结果、数据分析、结论等)。
▶ 实验流程

客户提供:新鲜样本/固定后的样本/包埋后的蜡块/切片和一抗,新鲜样本干冰运输;固定液样本、蜡块常温运输;石蜡切片、细胞爬片、组织芯片冰袋运输;冰冻切片冰袋+干冰运输;抗体冰袋运输。
▶ 实验步骤
1.石蜡切片脱蜡至水:依次将切片放入二甲苯Ⅰ 5min-二甲苯Ⅱ 5min-二甲苯 II5min-无水乙醇 1min-95%乙醇 1min-85%乙醇 1min-75%乙醇 1min-65%乙醇 1min,自来水洗。
2.抗原修复:将 EDTA 抗原修复液(PH9.0)用蒸馏水稀释 50 倍,并加热至沸腾。将脱蜡水化后的切片置于耐高温染色架上,放入不锈钢锅中;将功率调至最小(处于保温状态),盖上锅盖,继续加热 20 分钟后,离开热源,自然冷却 10 分钟;用自来水冲淋不锈钢锅外壁使之冷却,待锅中液体冷却至室温后取出切片;蒸馏水冲洗 3 分钟x3 次;用 PBS 溶液冲洗 3 分钟 x3 次;
3.灭活:除去 PBS,在切片上滴加内源性过氧化物酶阻断剂,室温下孵育 10 分钟,用PBS 溶液冲洗 3 分钟 x3 次;
4.封闭:除去 PBS,在切片上滴加 5%BSA 封闭液室温下孵育 30min;
5.加一抗:轻轻甩掉封闭液,切片上滴加第一抗体,室温孵育 1h,PBS 冲洗 3x3 分钟;
6.加二抗:除去 PBS,切片上滴加与一抗相应种属的二抗(HRP 标记),室温下孵育30 分钟,PBS 冲洗 3x3 分钟;
7.DAB 显色:除去 PBS,切片上滴加新鲜配制的 DAB 显色试剂显色(5min),显微镜下控制显色时间,阳性为棕黄色, 自来水冲洗切片终止显色。
8.复染细胞核:苏木素复染 5min 左右,自来水洗,1%盐酸乙醇分化数秒,自来水冲洗, 1%氨 水返蓝,自来水冲洗。
9.脱水封片:将切片依次放入 65%乙醇 1min-75%乙醇 1min-85%乙醇 1min -95%乙醇-无水乙醇 1min -二甲苯Ⅰ 5min 中脱水透明,将切片从二甲苯拿出来稍晾干,中性树胶封片。
10.显微镜镜检,图像采集分析。结果观察: 苏木素染细胞核为蓝色,DAB 显出的阳性表达为棕黄色
▶ 结果展示
小鼠肠ki67-20×
小鼠脑ki67-20×
小鼠肾ki67-20×
风险提示:丁香通仅作为第三方平台,为商家信息发布提供平台空间。用户咨询产品时请注意保护个人信息及财产安全,合理判断,谨慎选购商品,商家和用户对交易行为负责。对于医疗器械类产品,请先查证核实企业经营资质和医疗器械产品注册证情况。
技术资料暂无技术资料 索取技术资料